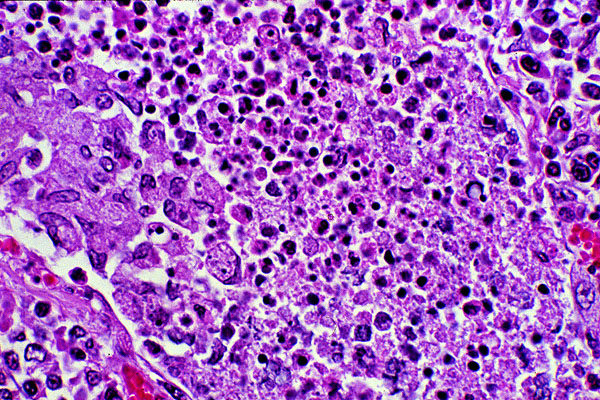

Abscess
Click picture to enlarge. Close window to return
This is the microscopic appearance of an abscess, consisting of degenerating neutrophils and other mononuclear inflammatory cells, with cell debris and necrosis of the underlying pulmonary parenchyma. The cell types may be difficult to recognize due to degeneration and fragmentation.